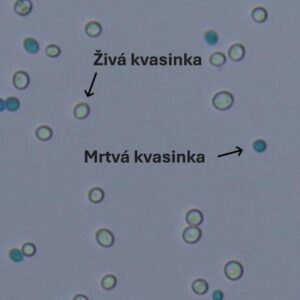

Kvasinky – zdraví na prvním místě
Všichni chceme, aby naše pivo bylo přesně podle našich představ, prostě to nejlepší v širokém okolí. Takové, kdy i tchán uznale přikývne a řekne: “To se Ti opravdu povedlo.”
Zdravé kvasinky jsou jednou z nutných podmínek. Ale co to znamená zdravé? Zdraví kvasinek se posuzuje dvěma základními charakteristikami, viabilitou a vitalitou.
Viabilita je poměr živých kvasinek vůči mrtvým ve vaší zákvasné dávce, tedy v kvasničném sudu či kvasničném vajíčku. Říká nám, kolik procent kvasinek je v mých “kvasnicích” vlastně živých. Viabilita se měří pomocí barvícího roztoku a Burkerovy komůrky spočítáním živých a mrtvých buněk. Pro správné určení bychom měli spočítat alespoň 500 kvasinek, což může zabrat klidně i hodinu. I když znám i neuvěřitelné profesionálky, co to dokáží pod 10 minut. Ale to jsou kouzelné postavy, které se tomu věnují více jak 10 let.
Kromě zdlouhavého času musí běžní smrtelníci bojovat ještě chybovostí, která je s počítám spojená. Existují samozřejmě různé profesionální řešení pro výpočet buněk či přímo kvasinek, ale skoro žádná z nich není upravené pro pivovarníky. Tady YeastMaster nabízí rychlé, jednoduché a spolehlivé řešení pro určení viability přímo pro pivovarníky.
V odborné literatuře se uvádí jako minimální doporučená viabilita 90%. Velké průmyslové pivovary používají jen kvasinky s viabilitou vyšší jak 95%. Jsou tak schopni dokonale řídit chuť svého piva a detailně plánovat ekonomiku provozu, protože dokáží přesně určit délku kvašení a tím i využití tanků a spilek s přesností kvašení až 12 hodin.
Přesto znám některé minipivovary, které používají kvasinky s viabilitou 85% a pivo je stále dobré. Ohledně jejich ekonomiky však detaily nevím.
Bohužel jsou i minipivovary, které vinou svých dodavatelů či svou neznalostí, používají kvasinky s viabilitou 75% a nižší a to je již silně poznat na chuti. A ne zrovna v pozitivním smyslu. Dalším nepříjemným projevem je delší primární kvašení často přesahující i 10 dní pro ležáky.
Druhou základní charakteristikou je vitalita. Ta nám říká o schopnosti kvasinek přeměnit cukry na alkohol. Jednoduše řečeno, jak moc se chce kvasinkám pracovat. Vitalita souvisí se stářím kvasinky, kolikrát se již dělila, jak moc je poškozené její DNA díky mutacím během mnoha kvašení a atd.
Vitalita se měří jako změna pH za čas v mladině. Naštěstí souvisí s viabilitou a dá se říci, že kvasinky s viabilitou 90% mají velkou vitalitu a jsou tedy připravé kvasit, což jim síly budou stačit.
Autor: Ondřej Sháněl